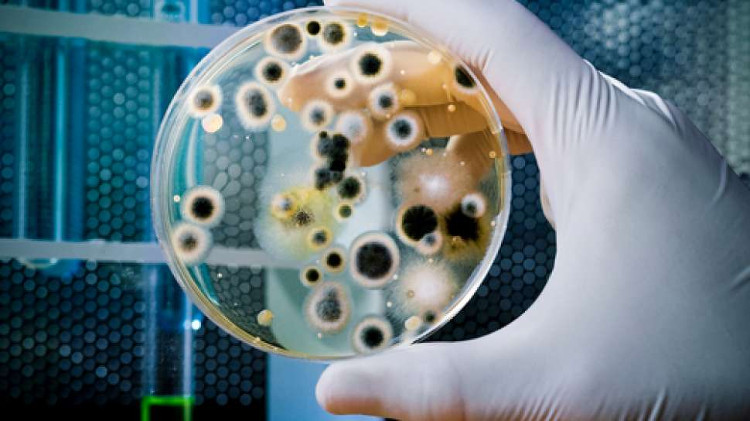
Các ion kali là thứ rất quan trọng đối với tất cả các tế bào.

Năm 2016, chúng ta đã có đủ mối lo về vi khuẩn, khi loại khuẩn có khả năng kháng tất cả các loại thuốc kháng sinh hiện nay đã xuất hiện và giết chết một người phụ nữ tại Mỹ.
Và đến nay, các chuyên gia còn phát hiện ra một sự thật còn đáng lo ngại hơn về lũ sinh vật đơn bào này. Hóa ra, chúng còn có thể liên lạc, "nói chuyện" với nhau bằng các tín hiệu điện từ, để cùng nhau thực hiện một nhiệm vụ "nguy hiểm".

Vi khuẩn có thể "nói chuyện" với nhau bằng các tín hiệu điện từ.
Cụ thể, các nhà khoa học thuộc ĐH California, San Diego (Mỹ) đã thực hiện nghiên cứu về màng sinh học - lớp màng tế bào hình thành ở bất cứ bề mặt nào có vi khuẩn sinh sôi, với chức năng bảo vệ vi khuẩn khỏi các tác nhân có hại từ môi trường bên ngoài.
Đây là một trong những mối đau đầu với khoa học, vì khi vi khuẩn hình thành màng sinh học, chúng sẽ rất khó loại bỏ. Theo thống kê, màng sinh học phải chịu trách nhiệm tới 80% trường hợp nhiễm trùng.
Và theo nhóm chuyên gia, vi khuẩn có thể phát ra những tín hiệu điện từ để thu hút nhiều loài vi khuẩn khác tụ tập, mở rộng tầm ảnh hưởng của màng sinh học.

Vi khuẩn có thể phát ra những tín hiệu điện từ để thu hút nhiều loài vi khuẩn khác tụ tập.
"Bằng cách này, vi khuẩn bên trong màng sinh học vẫn có thể thu hút những vi khuẩn bên ngoài để mở rộng địa bàn của chúng" - Gürol Süel, chủ nhiệm nghiên cứu cho biết.
Tuy vậy, tin tốt là khi phát hiện ra cách màng sinh học hình thành, chúng ta có thể tìm ra cách để phá vỡ chúng, tạo nên một bước đột phá cho ngành y học thế giới.
Nghiên cứu lần này được xây dựng dựa trên một giả thuyết trước kia, cho rằng vi khuẩn có thể liên lạc với nhau qua các tín hiệu điện từ, giống như các neuron thần kinh. Theo đó, chúng có thể phát ra các ion kali, truyền qua màng sinh học để phát tán ra môi trường ngoài.
Các ion kali là thứ rất quan trọng đối với tất cả các tế bào.
"Các ion kali là thứ rất quan trọng đối với tất cả các tế bào. Nó cho phép vi khuẩn liên lạc với nhau, thu hút để tạo thành một cộng đồng... đa chủng tộc" - Jacqueline Humphriesm, thành viên đội nghiên cứu cho biết.
Có một điểm thú vị khác, đó là các chuyên gia cho rằng vi khuẩn trong ruột và các tế bào ruột có thể liên lạc và hợp tác cùng nhau cũng bằng chính khả năng này.
Nghiên cứu được công bố trên tạp chí Cell.